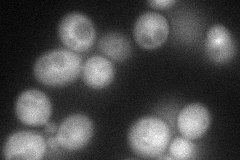
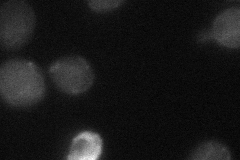
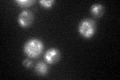
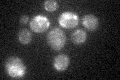

View description
Subunit of TORC1 (Tor1p or Tor2p-Kog1p-Lst8p-Tco89p), a complex that regulates growth in response to nutrient availability; cooperates with Ssd1p in the maintenance of cellular integrity; deletion strains are hypersensitive to rapamycin
Localization:
Intensity:
Fold change:
Significance:
-
C’ GFP library in SD

vacuole membrane25 -
N' NOP1pr-GFP in SD
cytosol,vacuole membrane50.7491 -
N' TEF2pr-mCherry in SD

cytosol27.5308 -
N' NATIVEpr-GFP in SD

vacuole membrane25.6127 -
N' TEF2pr-VC and Cyto-VN in SD
cytosol30.5944 -
C’ GFP library in SD+DTT
vacuole membrane26.431.05No -
C’ GFP library in SD+H2O2

vacuole membrane26.221.04No -
C’ GFP library in Starvation Media
vacuole membrane26.711.06No -
C’ GFP library on the background of Pup2-DaMP

vacuole membrane -
C’ GFP library on the background of CCT mutant

vacuole membrane26.71781.06845No
